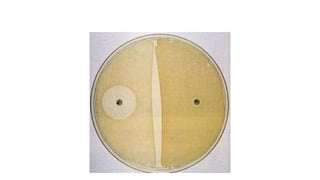
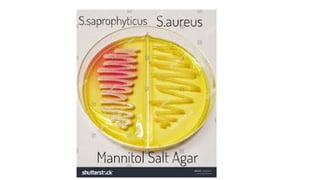

Embed presentation
Download to read offline











Coagulase-negative Staphylococcus aureus includes Staphylococcus epidermidis and Staphylococcus saprophyticus, both characterized as gram-positive cocci in clusters that are catalase positive and coagulase negative. They do not ferment mannitol and can be differentiated by novobiocin sensitivity, with S. saprophyticus being resistant. S. epidermidis is known to cause pyogenic infections related to prosthetic implants, while S. saprophyticus is associated with urinary tract infections.